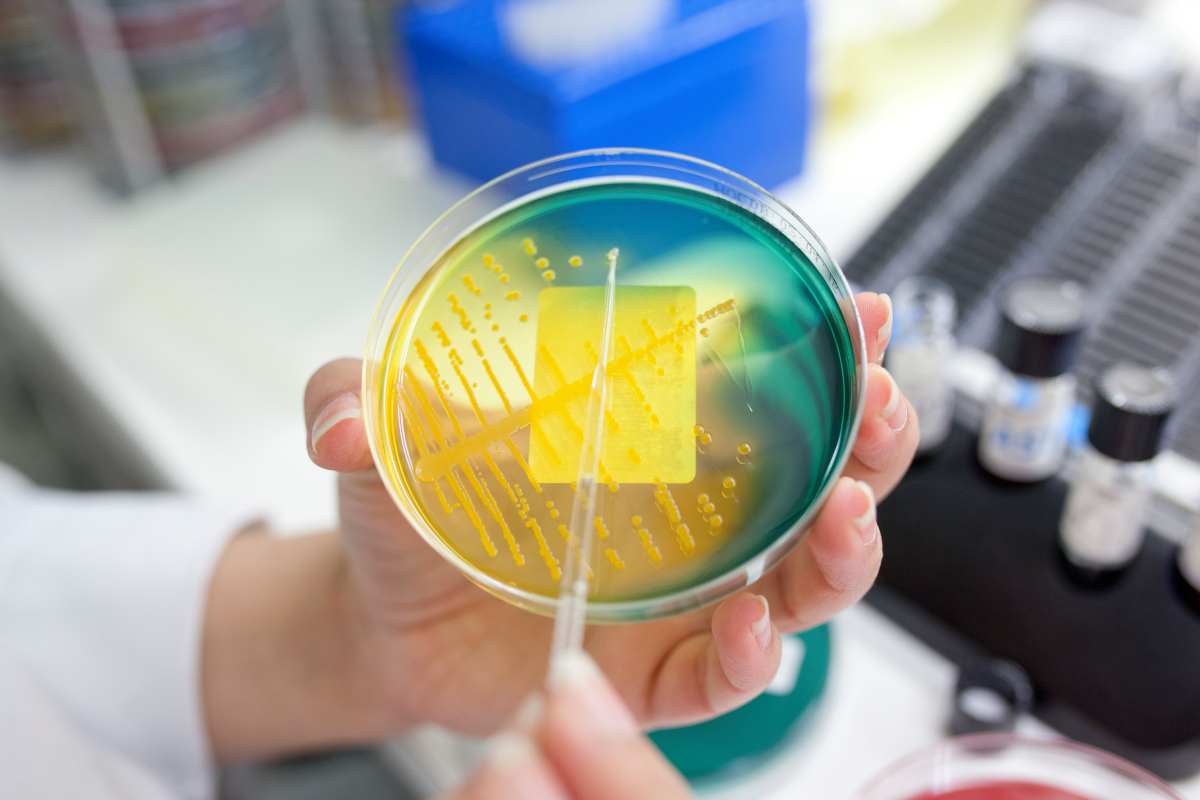
En hånd holder en petriskål med fargerik agar, gul og grønn. Gul bakteriekultur vises tydelig, med laboratorieutstyr i bakgrunnen.

Fagnettverk for NITO Bioingeniørfaglig institutt mikrobiologi
Dette er et fagnettverk for deg som er bioingeniør og som jobber med eller har interesse for mikrobiologi.

Fagnettverk for NITO Bioingeniørfaglig institutt mikrobiologi
For å se all informasjon eller bli med i nettverket må du logge inn. Er du ikke medlem, må du melde deg inn først.
Fordelene med å være med:
Utvid ditt faglige nettverk
Nettverket arbeider for erfaringsutveksling og kompetanseheving. Deltakerne oppfordres til å bruke nettverket aktivt til faglig utveksling og støtte.
Faglig oppdatering med våre fagkurs
Få tilgang til lenker til opptak av relevante digitale kurs.
Motta nyhetsbrev med aktuelt fagstoff
Jevnlige oppdateringer om utviklingen innen faget, nyheter, utlysninger, kurs og andre faglige arrangementer.
Delta på temamøter
Bli med på møter som dekker aktuelle temaer innen faget.
Nyhetsbrev fra fagnettverket mikrobiologi
Kontaktperson for fagnettverket
Mette Lundstrøm Dahl
Seniorrådgiver

Lurer du på noe?
Medlemstjenester
Mandag - fredag kl 09.00-15.00







